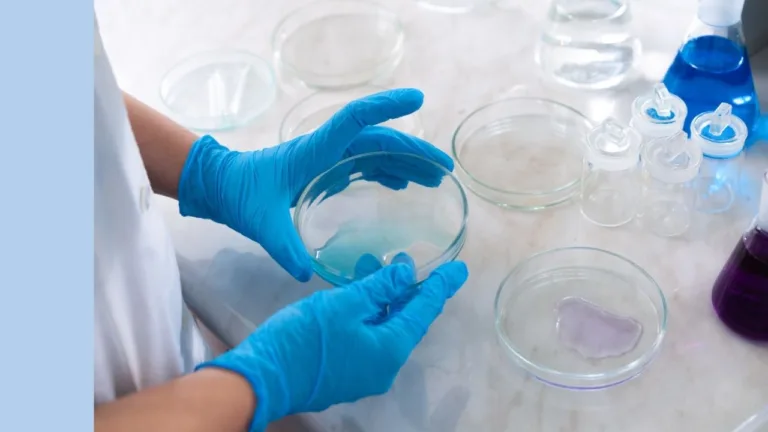
lab setting with a scientist looking at a petri dish

Sonic Healthcare (ASX: SHL) shares jump as earnings rebound and dividend lifts
Sonic Healthcare Ltd (ASX: SHL) shares are back in focus
Rask Media > CSL Limited (ASX:CSL)

CSL Limited (ASX: CSL) is Australia’s largest (and some might say best) healthcare company, specialising in biopharmaceuticals. Founded in the late 1900s as the Commonwealth Serum Laboratories, CSL was sold by the Australian Government to Australian investors via the share market in 1994 at $2.30 per share, at which time it doubled its size through an international acquisition. CSL is a global leader in blood plasma vaccines (think: the flu) and antivenoms, providing relief for potentially life-threatening medical conditions.
Sonic Healthcare Ltd (ASX: SHL) shares are back in focus

Pro Medicus (ASX:PME) drops 22% despite strong results. We unpack

CSL Limited (ASX: CSL) shares dropped more than 12% as

CSL Ltd (ASX: CSL) shares fell sharply late on Tuesday

Earnings season is back, and with it comes one of

ASX health care stocks were smashed in 2025. CSL collapsed,

Wide market dispersion, shifting sentiment, and unloved sectors may shape

The CSL Ltd (ASX:CSL) share price is in focus after

The CSL Ltd (ASX:CSL) share price is down more than
Want to level-up your analytical skills and investing insights but don’t know where to start? Join 50,000 Australian investors on our mailing list and we’ll send you our favourite podcasts, courses, resources and investment articles every Sunday morning. Grab a coffee and let Owen and the team bring you the best insights.
Here you go: A $50,000 per year passive income special report
Join more 50,000 Australian investors who read our weekly investing newsletter and we’ll send you our passive income investing report right now.
Simply enter your email address and we’ll send it to you. No tricks. Unsubscribe anytime.
Unsubscribe anytime. Read our Terms, Financial Services Guide, Privacy Policy. We’ll never sell your email address. Our company is Australian owned.